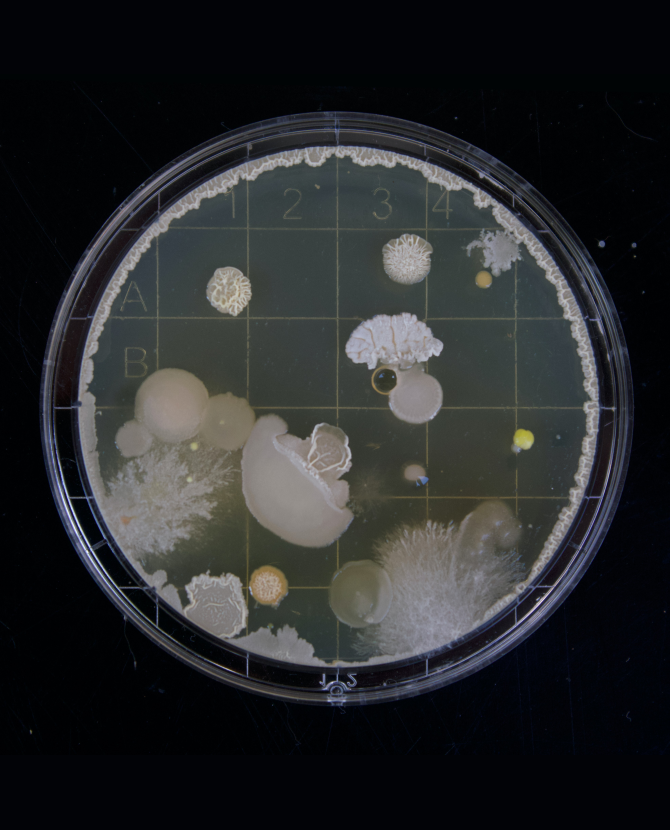

Я только спросить: собрали самые важные вопросы от читателей, на которые эксперты BURO. отвечали в 2020 году
Завели рубрику, в которой эксперты разбирают самые важные проблемы наших читателей, и вот о чем уже успели в ней написать

Что станет с моей кожей, если не брошу курить?
Вот сейчас готовьтесь сильно расстроиться — ну или выкурить последнюю в своей жизни сигарету. Да, мы серьезно.

Спать днем — вредно или полезно?
Спойлер: это зависит от продолжительности сна и времени, когда вы решили вздремнуть.

Как сесть на шпагат, если никогда не занимался растяжкой?
Мы бы сказали «никак», но женщина с идеальной растяжкой Самира Мустафаева настроена более оптимистично.

Что надо наносить сначала — консилер или тональный крем?
В статье на этот вопрос отвечали сразу шесть визажистов с мировым именем, и у каждого свое мнение. Готовый повод для интернет-спора.

Очень болит спина — что делать?
Точно что-то более серьезное, чем втирать мазь с ментолом или лежать на коврике с иголками.

Онлайн-приложение для анализа состава косметики — полезная штука?
Да, если использовать его без фанатизма и не позволять ему делать выбор за вас. Иначе недолго перейти на хендмейд-косметику из продуктов, которые лежат у вас в холодильнике.
Тестировать вакцину от коронавируса на себе — это опасно?
Врач-терапевт и сторонник доказательной медицины не призывает становиться волонтерами, но и не отговаривает от этого.
Статьи по теме
Подборка Buro 24/7


